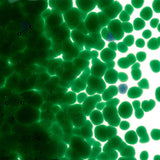

Kelly Green Transparent Frit - 2 oz Coarse Bullseye Glass FRIT-CRS-086-1145
Frit Info:
- Top quality Kelly Green Transparentfrit, fully compatible with fusible COE 90/Bullseye glasses.
- Coarse frit ranges in size from 2.7mm to 5.2mm, with each bag containing a wide range of sizes.
- 2 to 8 oz qty available - buy more for discounts.
-Glacial Art Glass offers a huge variety of fused glass supplies including COE 90 glass frit in over 100 different colors!
What is Glass Frit?:
Ever wonder how to make glass frit? Bullseye frit is produced by crushing, filtering, and magnetically purifying fusible Bullseye sheet glass. It has a wide range of uses in many different types of glass art projects and techniques including glassblowing, torchwork, and kiln fusing. Frit can also be used in cold processes such as mosaics or stained glass, to add a unique textural element.
Glass Frit comes in four size grades - coarse, medium, fine, and powder. This listing is for coarse grain frit. Coarse frit ranges in size from 2.7 to 5.2mm. In application, color saturation may vary when fusing frit onto sheet glass. Thin layers may be lighter in color, while thicker layers of frit may be darker and more saturated in color.
There is an endless palette of glass colors available to you - Glacial Art Glass offers nearly 120 different colors of frit glass to choose from! Use a single dense color in various sizes, create a beautiful gradient of one color to the next, or even use glass frit in a blend of colors!
In appearance, the finer the frit grain, the lighter the raw color will appear. This means that the larger grains of coarse frit will leave dense spots of color when they are fully fused to sheet glass. Even when fused in a group, these larger spots will sometimes stay distinct, meaning you can see a faint outline where each individual piece was resting on the sheet glass. This can create a beautiful, naturalistic pattern in fused glass.
When fusing glass in a kiln, COE 90 glass frit should only be used with other COE 90/Bullseye Compatible glasses.
How to use Kelly Green Transparent Glass Frit?
Use glass frit for your pâte de verre, frit painting, and kiln-casting projects, or add an eye-catching pop of color and texture to fused glass projects like sculptures and fused glass jewelry. Glacial art glass has created simple yet high quality fused glass tutorials, including basic and advanced microwave glass kiln tutorials.
Frit can be used in mosaics to create intricate patterns in any color
The coarse frit grains are like little brightly colored pebbles of glass, with uneven edges that have a more "raw" feeling than cut glass. Coarse frit comes in a wide range of sizes in a single bag, which gives it even more versatility. Frit can be used in any way you would use a small piece of glass, and is much safer and cleaner than broken glass bits.
Tack Fusing
Tack fusing frit (bringing it to a temperature that is lower than a full fuse, which means it retains more of its original shape) will create interesting textures and patterns on your piece. Different temperatures and times can be used to varying effect. To learn more about tack fusing not just glass frit, but all sorts of art glass - murrine, dots, cane, and stringer, click here to read our Tack Fuse/Contour Fuse Tutorial Tip Sheet.
You can even tack fuse frit in a Microwave Kiln.
Make Frit Balls
If you spread coarse frit on a kiln shelf in a single layer without any pieces touching, it will form individual near-spheres, which we call Frit Balls. These can be used in mosaics or beading projects, tack-fused to create larger textural forms, or they can be fused again for a more uniform circular footprint than the more rugged coarse grains. Click here for premade Frit Balls offered by Glacial Art Glass.
Frit can be cast in glass casting molds
Ceramic glass molds come in a wide array of all shapes and sizes! Typically, frit molds can be used with a mix of coarse, medium, and fine frit, which will fuse with fewer air bubbles. Casting coarse frit by itself will create more bubbles in your finished cast piece. Experiment and find your favorite techniques! To learn more about fusing frit with Glacial Art Glass murrine to make jewelry, click here to read our Glass Fusing Murrine and Frit Molds Tutorial Tip Sheet.